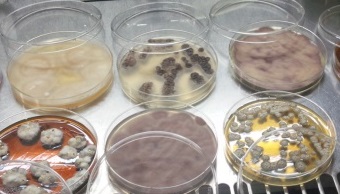
実験で使っている装置の写真

理研では、年に数回第3日曜日に科学技術館4Fシンラドーム(東京都千代田区)で、研究者とのトークイベント「理研DAY:研究者と話そう!」を開催しています。
土壌から単離した糸状菌(カビ)
土壌から単離した糸状菌(カビ)
目には見えない小さな生き物「微生物」はどこにでもいて、私たちの生活と密接に関わっています。例えば、医薬品や農薬の中にはそんな微生物が作った物質がもとになっているものが多くあります。1月の理研DAYでは、微生物の仲間である「カビ」がつくる薬のタネを探して、それらがどうやって作られるかを研究している加藤さんといろんなお話をします。
「微生物って何?」
「微生物はどこで採集するの?」
「カビは食べられるの?」
など詳しい話を直接研究者に聞いてみませんか?
| 開催日 | 2020年1月19日(日) 第1回 14:00-14:30 / 第2回 15:30-16:00 |
|---|---|
| 場所 | 科学技術館4階シンラドーム (東京都千代田区北の丸公園2-1) |
| 対象 | 一般 |
| 参加費 | 無料 ※但し、科学技術館入館料は必要です |
| 定員 | 各回62名様 ※当日先着順。科学技術館4階シンラドームにおいでください。 |
| 研究者 | 加藤 直樹(かとう なおき)研究員 ( 環境資源科学研究センター 天然物生合成研究ユニット) |
| テーマ | 「微生物がつくる薬の種」 |
| お問い合わせ | 理化学研究所広報室 Email: outreach-koho [at] riken.jp ※[at]は@に置き換えてください。 |
